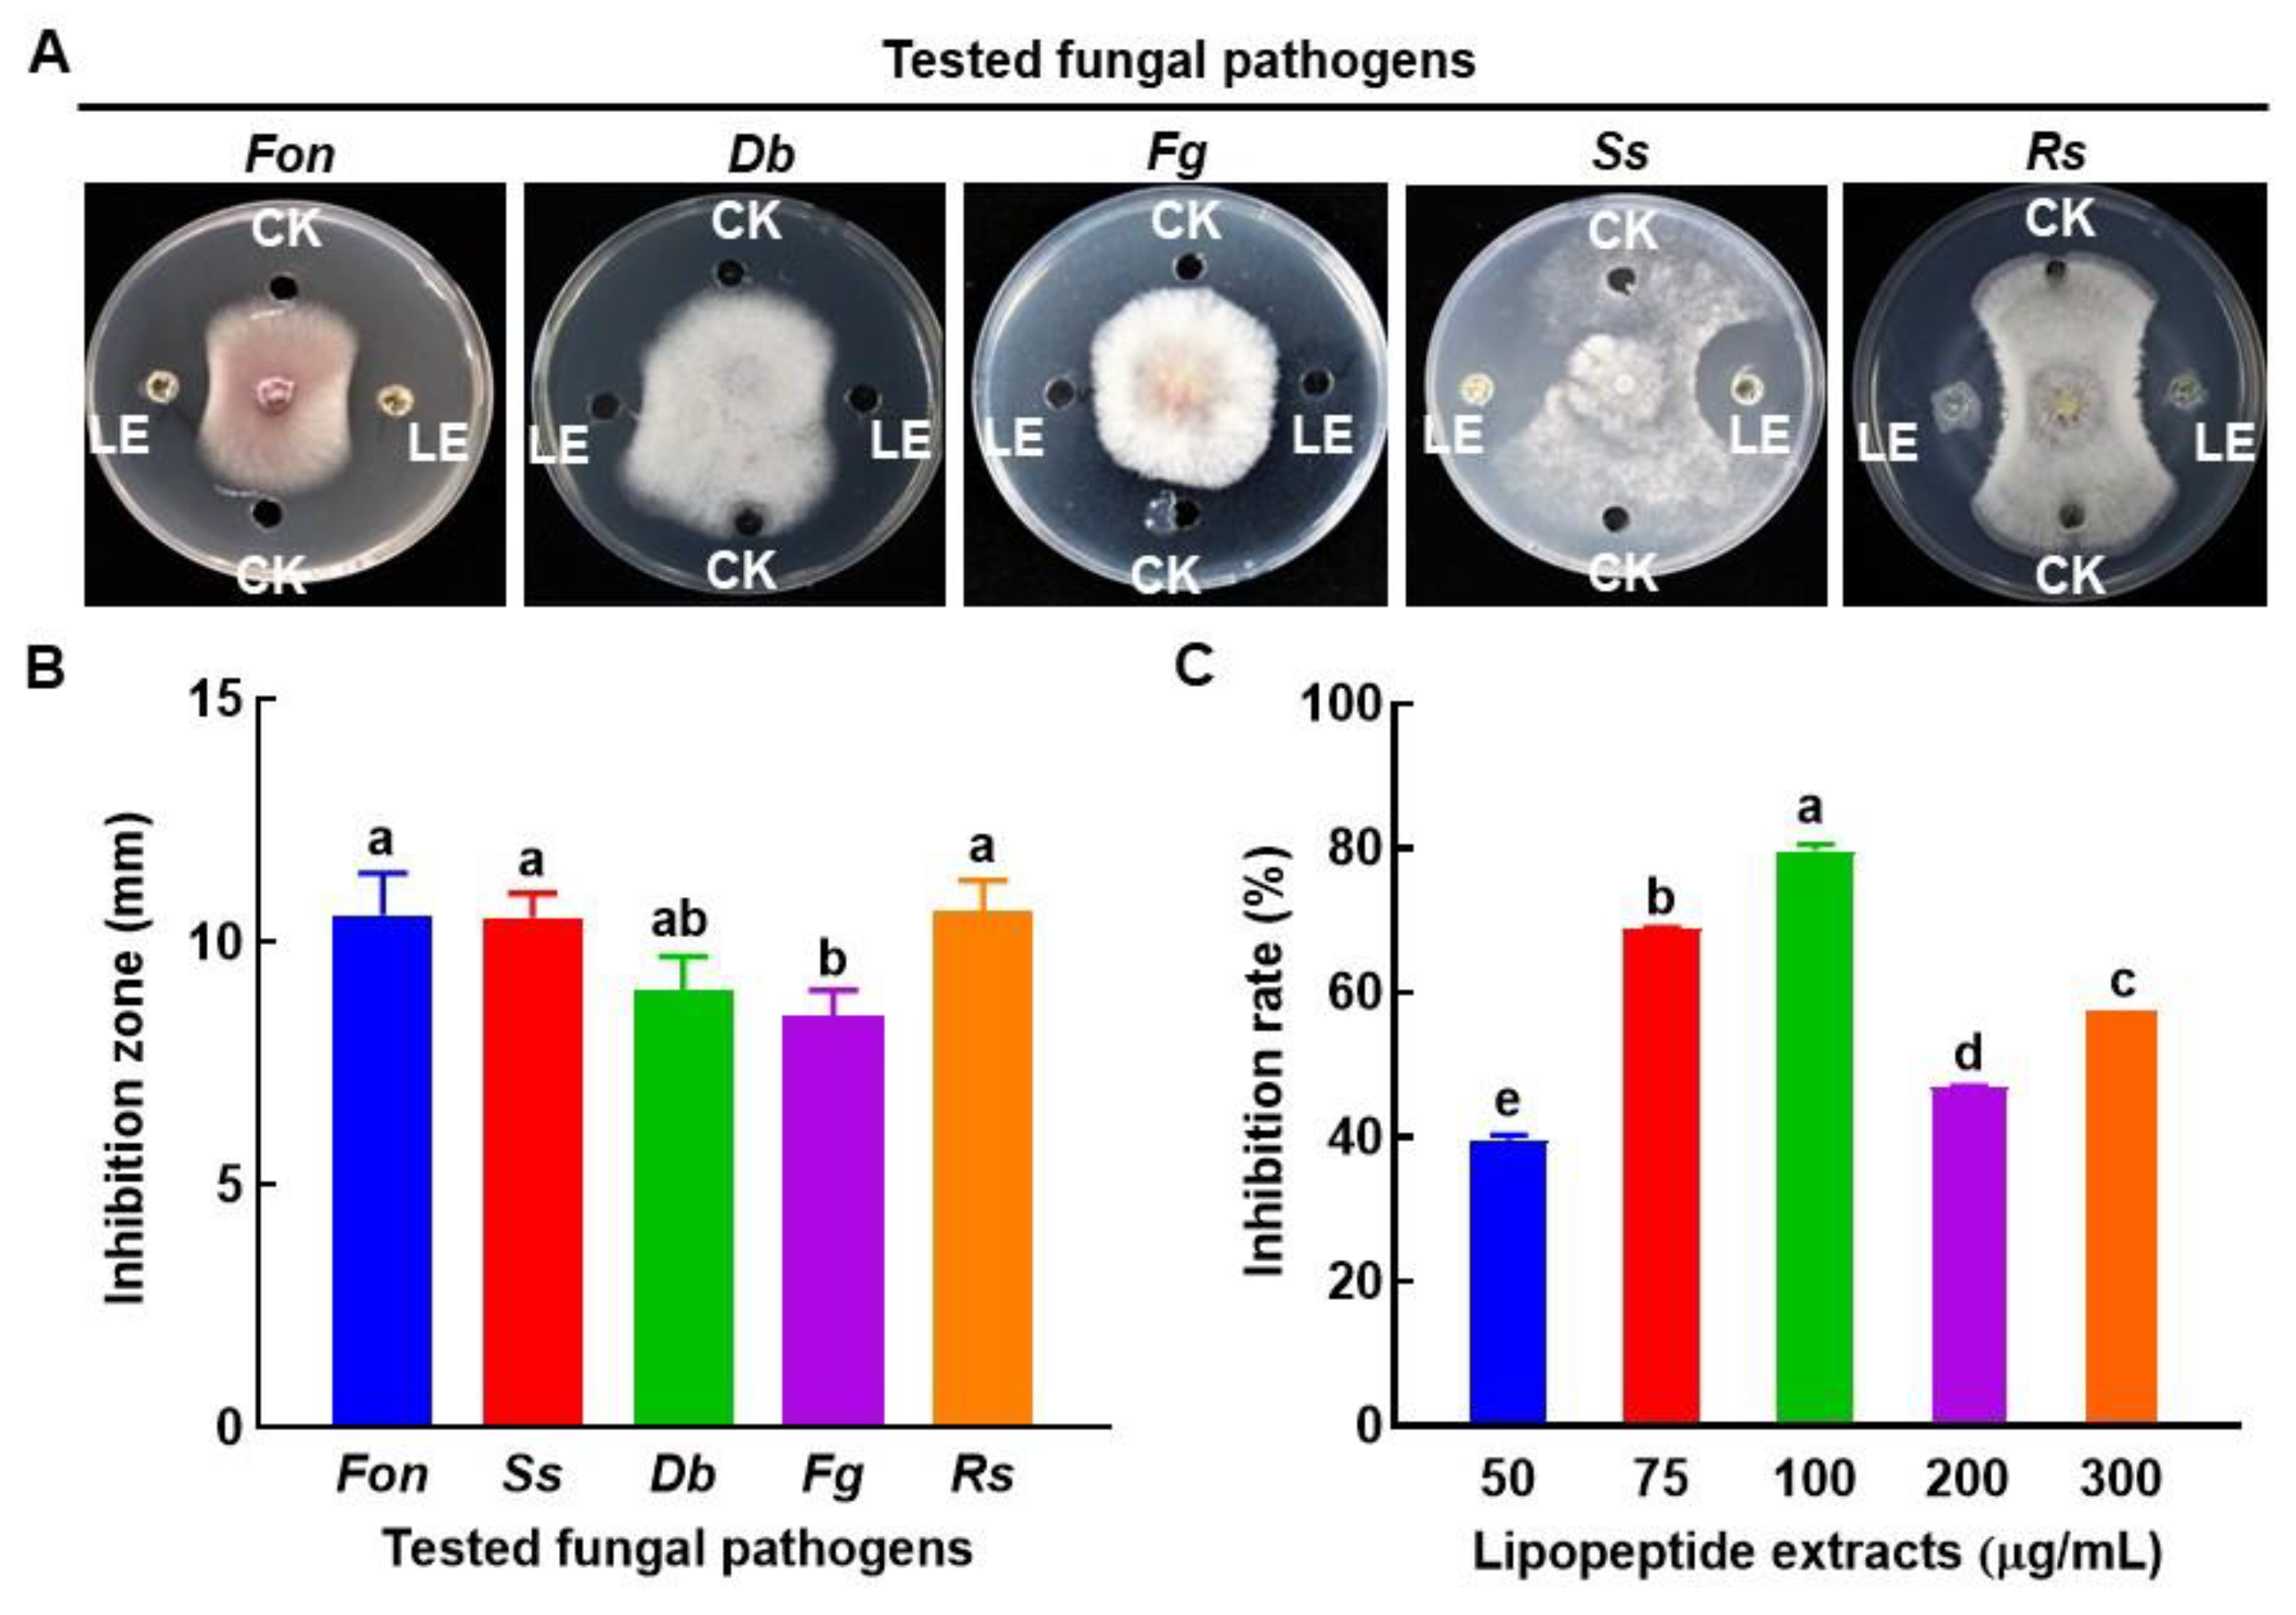
Jof 09 00336 g007

Suppression of Fusarium Wilt in Watermelon by Bacillus amyloliquefaciens DHA55 through Extracellular Production of Antifungal Lipopeptides
Abstract
1. Introduction
2. Materials and Methods
2.1. Soil Sampling and Bacterial Isolation
2.2. Screening of Antagonistic Bacterial Strains
2.3. Antifungal Activity of Cell-Free Filtrates of the Screened Antagonistic Bacterial Strains
2.4. Physiological and Biochemical Characterization of the Antagonistic Bacterial Strains
2.5. Growth Promotion and Disease Suppression Assays
2.6. DNA Extraction and Amplification of the 16S rRNA and Lipopeptide Biosynthesis Genes
2.7. Extraction, Purification, and Antagonistic Activity of Lipopeptides
2.8. Minimal Inhibitory Concentration Assay
2.9. Matrix-Assisted Laser Desorption/Ionization–Time of Flight (MALD-TOF) Analysis
2.10. Gas Chromatography–Mass Spectrometry (GC-MS) Analysis of Fatty Acids
2.11. Scanning Electron Microscope (SEM) Observation
2.12. Statistical Analysis
3. Results
3.1. Isolation of Antagonistic Bacterial Strains and Evaluation of Their Antifungal Activity against Pathogenic Fungi
3.2. Physiological and Biochemical Characterization of the Antagonistic Bacterial Strains
3.3. Growth-Promoting Activity of the Antagonistic Bacterial Strains
3.4. Biocontrol Efficacies of the Antagonistic Bacterial Strains against Watermelon Fusarium Wilt
3.5. Molecular Characterization of the Antagonistic Bacterial Strain DHA55
3.6. Antifungal Activity of Lipopeptides Produced by B. amyloliquefaciens DHA55
3.7. Identification of the Lipopeptide Biosynthesis Genes in B. amyloliquefaciens DHA55
3.8. Characterization of Lipopeptides Produced by B. amyloliquefaciens DHA55
3.9. Colonization of B. amyloliquefaciens DHA55 on Watermelon Roots
4. Discussion
5. Conclusions
Supplementary Materials
Author Contributions
Funding
Institutional Review Board Statement
Informed Consent Statement
Data Availability Statement
Conflicts of Interest
References
- Martyn, R.D. Fusarium wilt of watermelon: 120 years of research. Hort. Rev. 2014, 42, 349–442. [Google Scholar]
- Wu, Y.; Zhou, J.; Li, C.; Ma, Y.J. Antifungal and plant growth promotion activity of volatile organic compounds produced by Bacillus amyloliquefaciens. Microbiologyopen 2019, 8, e813. [Google Scholar] [CrossRef] [PubMed]
- Heydari, A.; Pessarakli, M. A review on biological control of fungal plant pathogens using microbial antagonists. J. Biol. Sci. 2010, 10, 273–290. [Google Scholar] [CrossRef]
- E, Y.; Yuan, J.; Yang, F.; Wang, L.; Ma, J.; Li, J.; Pu, X.; Raza, W.; Huang, Q.; Shen, Q. PGPR strain Paenibacillus polymyxa SQR-21 potentially benefits watermelon growth by re-shaping root protein expression. AMB Express 2017, 7, 104. [Google Scholar] [CrossRef]
- Raza, W.; Yuan, J.; Ling, N.; Huang, Q.W.; Shen, Q.R. Production of volatile organic compounds by an antagonistic strain Paenibacillus polymyxa WR-2 in the presence of root exudates and organic fertilizer and their antifungal activity against Fusarium oxysporum f. sp. niveum. Biol. Control 2015, 80, 89–95. [Google Scholar] [CrossRef]
- Zhu, J.; Tan, T.; Shen, A.; Yang, X.; Yu, Y.; Gao, C.; Li, Z.; Cheng, Y.; Chen, J.; Guo, L.; et al. Biocontrol potential of Bacillus subtilis IBFCBF-4 against Fusarium wilt of watermelon. J. Plant Pathol. 2020, 102, 433–441. [Google Scholar] [CrossRef]
- Jiang, C.H.; Yao, X.F.; Mi, D.D.; Li, Z.J.; Yang, B.Y.; Zheng, Y.; Qi, Y.; Guo, J. Comparative transcriptome analysis reveals the biocontrol mechanism of Bacillus velezensis F21 against Fusarium wilt on watermelon. Front. Microbiol. 2019, 10, 652. [Google Scholar] [CrossRef]
- Faheem, M.; Raza, W.; Zhong, W.; Nan, Z.; Shen, Q.; Xu, Y. Evaluation of the biocontrol potential of Streptomyces goshikiensis YCXU against Fusarium oxysporum f. sp. niveum. Biol. Control 2015, 81, 101–110. [Google Scholar] [CrossRef]
- De Cal, A.; Sztejnberg, A.; Sabuquillo, P.; Melgarejo, P. Management Fusarium wilt on melon and watermelon by Penicillium oxalicum. Biol. Control 2009, 51, 480–486. [Google Scholar] [CrossRef]
- Meyer, S.L.; Everts, K.L.; Gardener, B.M.; Masler, E.P.; Abdelnabby, H.M.E.; Skantar, A.M. Assessment of DAPG-producing Pseudomonas fluorescens for management of Meloidogyne incognita and Fusarium oxysporum on watermelon. J. Nematol. 2016, 48, 43–53. [Google Scholar] [CrossRef]
- Zhao, J.; Wang, Y.G.; Liang, H.; Huang, J.; Chen, Z.; Nie, Y.J. The rhizosphere microbial community response to a bio-organic fertilizer: Finding the mechanisms behind the suppression of watermelon Fusarium wilt disease. Acta Physiol. Plant 2018, 40, 17. [Google Scholar] [CrossRef]
- Wu, Z.; Huang, Y.; Li, Y.; Dong, J.; Liu, X.; Li, C. Biocontrol of Rhizoctonia solani via induction of the defense mechanism and antimicrobial compounds produced by Bacillus subtilis SL-44 on pepper (Capsicum annuum L.). Front. Microbiol. 2019, 10, 2676. [Google Scholar] [CrossRef] [PubMed]
- Kim, P.; Bai, H.; Bai, D.; Chae, H.; Chung, S.; Kim, Y.; Park, P.; Chi, T. Purification and characterization of a lipopeptide produced by Bacillus thuringiensis CMB26. J. Appl. Microbiol. 2004, 97, 942–949. [Google Scholar] [CrossRef]
- Yuan, J.; Raza, W.; Shen, Q.; Huang, Q. Antifungal activity of Bacillus amyloliquefaciens NJN-6 volatile compounds against Fusarium oxysporum f. sp. cubense. Appl. Environ. Microbiol. 2012, 78, 5942–5944. [Google Scholar] [CrossRef]
- Dang, Y.; Zhao, F.; Liu, X.; Fan, X.; Huang, R.; Gao, W.; Wang, S.; Yang, C. Enhanced production of antifungal lipopeptide iturin A by Bacillus amyloliquefaciens LL3 through metabolic engineering and culture conditions optimization. Microb. Cell Fact. 2019, 18, 68. [Google Scholar] [CrossRef] [PubMed]
- Vinodkumar, S.; Nakkeeran, S.; Renukadevi, P.; Malathi, V.G. Biocontrol potentials of antimicrobial peptide producing Bacillus species: Multifaceted antagonists for the management of stem rot of carnation caused by Sclerotinia sclerotiorum. Front. Microbiol. 2017, 8, 446. [Google Scholar] [CrossRef] [PubMed]
- Alvarez, F.; Castro, M.; Príncipe, A.; Borioli, G.; Fischer, S.; Mori, G.; Jofre, E. The plant-associated Bacillus amyloliquefaciens strains MEP218 and ARP23 capable of producing the cyclic lipopeptides iturin or surfactin and fengycin are effective in biocontrol of sclerotinia stem rot disease. J. Appl. Microbiol. 2012, 112, 159–174. [Google Scholar] [CrossRef]
- Chen, Y.; Yan, F.; Chai, Y.; Liu, H.; Kolter, R.; Losick, R.; Guo, J.H. Biocontrol of tomato wilt disease by Bacillus subtilis isolates from natural environments depends on conserved genes mediating biofilm formation. Environ. Microbiol. 2013, 15, 848–864. [Google Scholar] [CrossRef]
- Mehmood, Z.; Ahmad, I.; Mohammad, F.; Ahmad, S. Indian medicinal plants: A potential source for anticandidal drugs. Pharm. Biol. 1999, 37, 3237–3242. [Google Scholar] [CrossRef]
- Xu, W.; Wang, H.; Lv, Z.; Shi, Y.; Wang, Z. Antifungal activity and functional components of cell-free supernatant from Bacillus amyloliquefaciens LZN01 inhibit Fusarium oxysporum f. sp. niveum growth. Biotech. Biotechnol. Equip. 2019, 33, 1042–1052. [Google Scholar] [CrossRef]
- Wan, W.; Qin, Y.; Wu, H.; Zuo, W.; He, H.; Tan, J.; Wang, Y.; He, D. Isolation and characterization of phosphorus solubilizing bacteria with multiple phosphorus sources utilizing capability and their potential for lead immobilization in soil. Front. Microbiol. 2020, 11, 752. [Google Scholar] [CrossRef] [PubMed]
- Ramesh, A.; Sharma, S.K.; Sharma, M.P.; Yadav, N.; Joshi, O.P. Inoculation of zinc solubilizing Bacillus aryabhattai strains for improved growth, mobilization and biofortification of zinc in soybean and wheat cultivated in Vertisols of central. Appl. Soil Ecol. 2014, 73, 87–96. [Google Scholar] [CrossRef]
- Bric, J.M.; Bostock, R.M.; Silverstone, S.E. Rapid in situ assay for indoleacetic acid production by bacteria immobilized on a nitrocellulose membrane. Appl. Environ. Microbiol. 1991, 57, 535–538. [Google Scholar] [CrossRef] [PubMed]
- Benidire, L.; Pereira, S.I.; Castro, P.M.; Boularbah, A. Assessment of plant growth promoting bacterial populations in the rhizosphere of metallophytes from the Kettara mine, Marrakech. Environ. Sci. Pollut. Res. Int. 2016, 23, 21751–21765. [Google Scholar] [CrossRef] [PubMed]
- Ghazy, N.; El-Nahraw, S. Siderophore production by Bacillus subtilis MF497446 and Pseudomonas koreensis MG209738 and their efficacy in controlling Cephalosporium maydis in maize plant. Archi. Microbiol. 2021, 203, 1195–1209. [Google Scholar] [CrossRef]
- Abd El-Rahman, A.F.; Shaheen, H.A.; Abd El-Aziz, R.M.; Ibrahim, D.S.S. Influence of hydrogen cyanide-producing rhizobacteria in controlling the crown gall and root-knot nematode, Meloidogyne incognita. Egyp. J. Biol. Pest Cont. 2019, 29, 41. [Google Scholar] [CrossRef]
- Bhattacharyya, C.; Banerjee, S.; Acharya, U.; Mitra, A.; Mallick, I.; Haldar, A.; Haldar, S.; Ghosh, A.; Ghosh, A. Evaluation of plant growth promotion properties and induction of antioxidative defense mechanism by tea rhizobacteria of Darjeeling, India. Sci. Rep. 2020, 10, 15536. [Google Scholar] [CrossRef]
- Barrow, G.I.; Feltham, R.K.A. Cowan and Steel’s Manual for the Identification of Medical Bacteria, 3rd ed.; Cambridge University Press: Cambridge, UK; London, UK, 1993. [Google Scholar]
- Shah, D.; Khan, M.S.; Aziz, S.; Ali, H.; Pecoraro, L. Molecular and biochemical characterization, antimicrobial activity, stress tolerance, and plant growth-promoting effect of endophytic bacteria isolated from wheat varieties. Microorganisms 2021, 10, 21. [Google Scholar] [CrossRef]
- Hoffland, E.; van den Boogaard, R.; Nelemans, J.; Findenegg, G. Biosynthesis and root exudation of citric and malic acids in phosphate-starved rape plants. New Phytol. 1992, 122, 675–680. [Google Scholar] [CrossRef]
- Chen, L.; Yang, X.; Raza, W.; Li, J.; Liu, Y.; Qiu, M.; Zhang, F.; Shen, Q. Trichoderma harzianum SQR-T037 rapidly degrades allelochemicals in rhizospheres of continuously cropped cucumbers. Appl. Microbiol. Biotechnol. 2011, 89, 1653–1663. [Google Scholar] [CrossRef]
- Huang, X.; Shi, D.; Sun, F.; Lu, H.; Liu, J.; Wu, W. Efficacy of sludge and manure compost amendments against Fusarium wilt of cucumber. Environ. Sci. Pollut. Res. Int. 2012, 19, 3895–3905. [Google Scholar] [CrossRef]
- Li, B.; Xu, L.; Lou, M.; Li, F.; Zhang, Y.; Xie, G.J. Isolation and characterization of antagonistic bacteria against bacterial leaf spot of Euphorbia pulcherrima. Lett. Appl. Microbiol. 2008, 46, 450–455. [Google Scholar] [CrossRef] [PubMed]
- Thompson, J.D.; Gibson, T.J.; Plewniak, F.; Jeanmougin, F.; Higgins, D.G. The CLUSTAL_X windows interface: Flexible strategies for multiple sequence alignment aided by quality analysis tools. Nucl. Acids Res. 1997, 25, 4876–4882. [Google Scholar] [CrossRef]
- Tamura, K.; Peterson, D.; Peterson, N.; Stecher, G.; Nei, M.; Kumar, S. MEGA5: Molecular evolutionary genetics analysis using maximum likelihood, evolutionary distance, and maximum parsimony methods. Mol. Biol. Evol. 2011, 28, 2731–2739. [Google Scholar] [CrossRef]
- Balouirin, M.; Sadiki, M.; Ibnsouda, S.K. Methods for in vitro evaluating antimicrobial activity: A review. J. Pharmac. Anal. 2016, 6, 71–79. [Google Scholar] [CrossRef]
- Xu, Z.; Shao, J.; Li, B.; Yan, X.; Shen, Q.; Zhang, R. Contribution of bacillomycin D in Bacillus amyloliquefaciens SQR9 to antifungal activity and biofilm formation. Appl. Environ. Microbiol. 2013, 79, 808–815. [Google Scholar] [CrossRef] [PubMed]
- Kaur, T.; Kaur, A.; Sharma, V.; Manhas, R.K. Purification and characterization of a new antifungal compound 10-(2,2-dimethyl-cyclohexyl)-6,9- dihydroxy-4,9-dimethyl-dec-2-enoic acid methyl ester from Streptomyces hydrogenans strain DH16. Front. Microbiol. 2016, 7, 1004. [Google Scholar] [CrossRef]
- Ben Ayed, H.; Hmidet, N.; Béchet, M.; Chollet, M.; Chataigné, G.; Leclère, V.; Jacques, P.; Nasri, M. Identification and biochemical characteristics of lipopeptides from Bacillus mojavensis A21. Process Biochem. 2014, 49, 1699–1707. [Google Scholar] [CrossRef]
- Sasser, M. Identification of Bacteria by Gas Chromatography of Cellular Fatty Acids; MIDI Technical Note 101; MIDI Inc.: Newark, DE, USA, 1990. [Google Scholar]
- Dai, Y.; Cao, Z.; Huang, L.; Liu, S.; Shen, Z.; Wang, Y.; Wang, H.; Zhang, H.; Li, D.; Song, F. CCR4-Not complex subunit Not2 plays critical roles in vegetative growth, conidiation and virulence in watermelon Fusarium wilt pathogen Fusarium oxysporum f. sp. niveum. Front. Microbiol. 2016, 7, 1449. [Google Scholar] [CrossRef]
- Nehra, V.; Choudhary, M. A review on plant growth promoting rhizobacteria acting as bioinoculants and their biological approach towards the production of sustainable agriculture. J. Appl. Nat. Sci. 2015, 7, 540–556. [Google Scholar] [CrossRef]
- Jiao, X.; Takishita, Y.; Zhou, G.; Smith, D.L. Plant associated rhizobacteria for biocontrol and plant growth enhancement. Front. Plant Sci. 2021, 12, 634796. [Google Scholar] [CrossRef]
- Numan, M.; Bashir, S.; Khan, Y.; Mumtaz, R.; Shinwari, Z.K.; Khan, A.L.; Khan, A.; Alharrasi, A. Plant growth promoting bacteria as an alternative strategy for salt tolerance in plants: A review. Microbiol. Res. 2018, 209, 21–32. [Google Scholar] [CrossRef] [PubMed]
- Backer, R.; Rokem, J.S.; Ilangumaran, G.; Lamont, J.; Praslickova, D.; Ricci, E.; Subramanian, A.; Smith, D. Plant growth-promoting rhizobacteria: Context, mechanisms of action, and roadmap to commercialization of biostimulants for sustainable agriculture. Front. Plant Sci. 2018, 9, 1473. [Google Scholar] [CrossRef] [PubMed]
- Pršić, J.; Ongena, M. Elicitors of plant immunity triggered by beneficial bacteria. Front. Plant Sci. 2020, 11, 594530. [Google Scholar] [CrossRef]
- Oleńska, E.; Małek, W.; Wójcik, M.; Swiecicka, I.; Thijs, S.; Vangronsveld, J. Beneficial features of plant growth-promoting rhizobacteria for improving plant growth and health in challenging conditions: A methodical review. Sci. Total Environ. 2020, 743, 140682. [Google Scholar] [CrossRef]
- Ali, S.; Hameed, S.; Imran, A.; Iqbal, M.; Lazarovits, G. Genetic, physiological and biochemical characterization of Bacillus sp. strain RMB7 exhibiting plant growth promoting and broad spectrum antifungal activities. Microb. Cell Fact. 2014, 13, 144. [Google Scholar] [CrossRef]
- Hashem, A.; Tabassum, B.; Fathi Abd Allah, E. Bacillus subtilis: A plant-growth promoting rhizobacterium that also impacts biotic stress. Saudi J. Biol. Sci. 2019, 26, 1291–1297. [Google Scholar] [CrossRef] [PubMed]
- Masum, M.M.I.; Liu, L.; Yang, M.; Hossain, M.M.; Siddiqa, M.M.; Supty, M.E.; Ogunyemi, S.O.; Hossain, A.; An, Q.; Li, B. Halotolerant bacteria belonging to operational group Bacillus amyloliquefaciens in biocontrol of the rice brown stripe pathogen Acidovorax oryzae. J. Appl. Microbiol. 2018, 125, 1852–1867. [Google Scholar] [CrossRef]
- Li, X.; Zhang, Y.; Wei, Z.; Guan, Z.; Cai, Y.; Liao, X. Antifungal activity of isolated Bacillus amyloliquefaciens SYBC H47 for the biocontrol of peach gummosis. PLoS ONE 2016, 11, e0162125. [Google Scholar] [CrossRef]
- Yi, Y.; Shan, Y.; Liu, S.; Yang, Y.; Liu, Y.; Yin, Y.; Hou, Z.; Luan, P.; Li, R. Antagonistic strain Bacillus amyloliquefaciens XZ34-1 for controlling Bipolaris sorokiniana and promoting growth in wheat. Pathogens 2021, 10, 1526. [Google Scholar] [CrossRef]
- Luo, L.; Zhao, C.; Wang, E.; Raza, A.; Yin, C. Bacillus amyloliquefaciens as an excellent agent for biofertilizer and biocontrol in agriculture: An overview for its mechanisms. Microbiol. Res. 2022, 259, 127016. [Google Scholar] [CrossRef] [PubMed]
- Jiao, R.; Cai, Y.; He, P.; Munir, S.; Li, X.; Wu, Y.; Wang, J.; Xia, M.; He, P.; Wang, G.; et al. Bacillus amyloliquefaciens YN201732 produces lipopeptides with promising biocontrol activity against fungal pathogen Erysiphe cichoracearum. Front. Cell. Infect. Microbiol. 2021, 11, 598999. [Google Scholar] [CrossRef]
- Kazerooni, E.A.; Maharachchikumbura, S.S.N.; Al-Sadi, A.M.; Kang, S.M.; Yun, B.W.; Lee, I.J. Biocontrol potential of Bacillus amyloliquefaciens against Botrytis pelargonii and Alternaria alternata on Capsicum annuum. J. Fungi 2021, 7, 472. [Google Scholar] [CrossRef]
- Xu, X.; Wang, Y.; Lei, T.; Sohail, M.A.; Wang, J.; Wang, H. Synergistic effects of Bacillus amyloliquefaciens SDTB009 and difenoconazole on Fusarium wilt of tomato. Plant Dis. 2022, 106, 2165–2171. [Google Scholar] [CrossRef]
- Wang, H.; Wang, Z.; Liu, Z.; Wang, K.; Xu, W. Membrane disruption of Fusarium oxysporum f. sp. niveum induced by myriocin from Bacillus amyloliquefaciens LZN01. Microb. Biotechnol. 2021, 14, 517–534. [Google Scholar] [CrossRef]
- Wang, H.; Wang, Z.; Xu, W.; Wang, K. Comprehensive transcriptomic and proteomic analyses identify intracellular targets for myriocin to induce Fusarium oxysporum f. sp. niveum cell death. Microb. Cell Fact. 2021, 20, 69. [Google Scholar] [CrossRef] [PubMed]
- Kang, B.R.; Park, J.S.; Jung, W.J. Antifungal evaluation of fengycin isoforms isolated from Bacillus amyloliquefaciens PPL against Fusarium oxysporum f. sp. lycopersici. Microb. Pathog. 2020, 149, 104509. [Google Scholar] [CrossRef]
- Chen, N.; Jin, M.; Qu, H.M.; Chen, Z.Q.; Chen, Z.L.; Qiu, Z.G.; Wang, X.W.; Li, J.W. Isolation and characterization of Bacillus sp. producing broad-spectrum antibiotics against human and plant pathogenic fungi. J. Microbiol. Biotechnol. 2012, 22, 256–263. [Google Scholar] [CrossRef]
- Torres, M.J.; Brandan, C.P.; Petroselli, G.; Erra-Balsells, R.; Audisio, M.C. Antagonistic effects of Bacillus subtilis subsp. subtilis and B. amyloliquefaciens against Macrophomina phaseolina: SEM study of fungal changes and UV-MALDI-TOF MS analysis of their bioactive compounds. Microbiol. Res. 2016, 182, 31–39. [Google Scholar] [CrossRef]
- Saechow, S.; Thammasittirong, A.; Kittakoop, P.; Prachya, S.; Thammasittirong, S. Antagonistic activity against dirty panicle rice fungal pathogens and plant growth-promoting activity of Bacillus amyloliquefaciens BAS23. J. Microbiol. Biotechnol. 2018, 28, 1527–1535. [Google Scholar] [CrossRef]
- Islam, S.; Akanda, A.M.; Prova, A.; Islam, M.T.; Hossain, M.M. Isolation and identification of plant growth promoting rhizobacteria from cucumber rhizosphere and their effect on plant growth promotion and disease suppression. Front. Microbiol. 2016, 6, 1360. [Google Scholar] [CrossRef] [PubMed]
- Wu, S.; Liu, G.; Zhou, S.; Sha, Z.; Sun, C. Characterization of antifungal lipopeptide biosurfactants produced by marine bacterium Bacillus sp. CS30. Mar. Drugs 2019, 17, 199. [Google Scholar] [CrossRef]
- Kalai-Grami, L.; Karkouch, I.; Naili, O.; Slimene, I.B.; Elkahoui, S.; Zekri, R.B.; Hattab, M.M.; Hajlaoui, M.R.; Limam, F. Production and identification of iturin A lipopeptide from Bacillus methyltrophicus TEB1 for control of Phoma tracheiphila. J. Basic Microbiol. 2016, 56, 864–871. [Google Scholar] [CrossRef] [PubMed]
- Gao, L.; Han, J.; Liu, H.; Qu, X.; Lu, Z.; Bie, X. Plipastatin and surfactin coproduction by Bacillus subtilis pB2-L and their effects on microorganisms. Antonie Leeuwenhoek 2017, 110, 1007–1018. [Google Scholar] [CrossRef] [PubMed]
- Płaza, G.; Chojniak, J.; Rudnicka, K.; Paraszkiewicz, K.; Bernat, P. Detection of biosurfactants in Bacillus species: Genes and products identification. J. Appl. Microbiol. 2015, 119, 1023–1034. [Google Scholar] [CrossRef] [PubMed]
- Jemil, N.; Manresa, A.; Rabanal, F.; Ayed, H.B.; Hmidet, N.; Nasri, M. Structural characterization and identification of cyclic lipopeptides produced by Bacillus methylotrophicus DCS1 strain. J. Chromatogr. B Analyt. Technol. Biomed. Life Sci. 2017, 1060, 374–386. [Google Scholar] [CrossRef] [PubMed]
- Abdellaziz, L.; Chollet, M.; Abderrahmani, A.; Béchet, M.; Yaici, L.; Chataigné, G.; Arias, A.A.; Leclere, V.; Jacques, P. Lipopeptide biodiversity in antifungal Bacillus strains isolated from Algeria. Arch. Microbiol. 2018, 200, 1205–1216. [Google Scholar] [CrossRef]
- Dimkić, I.; Stanković, S.; Nišavić, M.; Petković, M.; Ristivojević, P.; Fira, D.; Berić, T. The profile and antimicrobial activity of Bacillus lipopeptide extracts of five potential biocontrol strains. Front. Microbiol. 2017, 8, 925. [Google Scholar] [CrossRef]
- Toral, L.; Rodríguez, M.; Bejar, V.; Sampedro, I. Antifungal activity of lipopeptides from Bacillus XT1 CECT 8661 against Botrytis cinerea. Front. Microbiol. 2018, 9, 1315. [Google Scholar] [CrossRef]
- Hazarika, D.J.; Goswami, G.; Gautom, T.; Parveen, A.; Das, P.; Barooah, M.; Boro, R.C. Lipopeptide mediated biocontrol activity of endophytic Bacillus subtilis against fungal phytopathogens. BMC Microbiol. 2019, 19, 71. [Google Scholar] [CrossRef]
- Joshi, R.; Brian, B. Identification and characterization of novel genetic markers associated with biological control activities in Bacillus subtilis. Phytopathology 2006, 96, 145–154. [Google Scholar] [CrossRef] [PubMed]
- Cao, Y.; Xu, Z.; Ling, N.; Yuan, Y.; Yang, X.; Chen, L.; Shen, B.; Shen, Q. Isolation and identification of lipopeptides produced by B. subtilis SQR 9 for suppressing Fusarium wilt of cucumber. Sci. Hort. 2012, 135, 32–39. [Google Scholar] [CrossRef]
- Zhang, Q.X.; Zhang, Y.; Shan, H.H.; Tong, Y.H.; Chen, X.J.; Liu, F.Q. Isolation and identification of antifungal peptides from Bacillus amyloliquefaciens W10. Environ. Sci. Pollut. Res. Int. 2017, 24, 25000–25009. [Google Scholar] [CrossRef]
- Vessey, J.K. Plant growth promoting rhizobacteria as biofertilizers. Plant Soil 2003, 255, 571–586. [Google Scholar] [CrossRef]
- Liu, D.; Li, K.; Hu, J.; Wang, W.; Liu, X.; Gao, Z. Biocontrol and action mechanism of Bacillus amyloliquefaciens and Bacillus subtilis in soybean Phytophthora blight. Int. J. Mol. Sci. 2019, 20, 2908. [Google Scholar] [CrossRef]
- Vitullo, D.; di Pietro, A.; Romano, A.; Lanzotti, V.; Lima, G.J. Role of new bacterial surfactins in the antifungal interaction between Bacillus amyloliquefaciens and Fusarium oxysporum. Plant Pathol. 2012, 61, 689–699. [Google Scholar] [CrossRef]
- Cao, Y.; Zhang, Z.; Ling, N.; Yuan, Y.; Zheng, X.; Shen, B.; Shen, Q. Bacillus subtilis SQR9 can control Fusarium wilt in cucumber by colonizing plant roots. Biol. Fert. Soils 2011, 47, 495–506. [Google Scholar] [CrossRef]
- Zehra, A.; Raytekar, N.A.; Meena, M.; Swapnil, P. Efficiency of microbial bio-agents as elicitors in plant defense mechanism under biotic stress: A review. Curr. Res. Microb. Sci. 2021, 2, 100054. [Google Scholar] [CrossRef]
- Choudhary, D.K.; Johri, B.N. Interactions of Bacillus spp. and plants—With special reference to induced systemic resistance (ISR). Microbiol. Res. 2009, 164, 493–513. [Google Scholar] [CrossRef]
- Madriz-Ordeñana, K.; Pazarlar, S.; Jørgensen, H.J.L.; Nielsen, T.K.; Zhang, Y.; Nielsen, K.L.; Hansen, L.H.; Thordal-Christensen, H. The Bacillus cereus strain EC9 primes the plant immune system for superior biocontrol of Fusarium oxysporum. Plants 2022, 11, 687. [Google Scholar] [CrossRef]

| Lipopeptides | Primers | Sequence (5′–3′) | Genes | Size (bp) |
|---|---|---|---|---|
| Iturin | BamB1F | CGACATACAGTTCTCCCCGGT | ItuB | 473 |
| BamB1R | AAGAAGGCGTTTTTCAAGCA | |||
| ITUCF1 | TACGGAGGAGAAAACAGTGC | ItuC | 450 | |
| ITUCR3 | ACCTCTGGCACAAAGGGGTG | |||
| ItuD2F | GACGGTAGATTCGCTGCTGT | ItuD | 593 | |
| ItuD2R | TGATGCGATCTCCTTGGATG | |||
| Fengycin | FNDF1 | CTGGGAGGTCAGCCGGTCTG | FenD | 167 |
| FNDR1 | GTGGTCGCCGGTTCACAAAT | |||
| FenB1F | CCCTTGTCAGAAACAGCAAT | FenE | 704 | |
| FenB1R | GCTTCTATTTCGGCAGGCTC | |||
| Surfactin | 110F | TATAAGCCGGCAGCGAGCTG | SrfAB | 202 |
| 110R | GAGTGTCTGTTTCCAAATGC |
| Strains | Shape | Gram Staining | Cat. a | Prot. a | Cel. a | Amm. a | HCN a | PSI (mm) a,b | Siderophore (mm) b | IAA (μg/mL) a |
|---|---|---|---|---|---|---|---|---|---|---|
| DHA4 | Rod | + | + | + | + | + | − | 0.38 ± 0.01 | 0.53 ± 0.19 | 394.90 |
| DHA6 | Rod | + | + | + | + | + | − | 0.45 ± 0.07 | 0.51 ± 0.19 | 420.05 |
| DHA10 | Rod | + | + | + | + | + | − | 0.36 ± 0.01 | 0.49 ± 0.19 | 327.19 |
| DHA12 | Rod | + | + | + | + | + | − | 0.36 ± 0.01 | 0.49 ± 0.18 | 165.05 |
| DHA41 | Rod | + | + | + | + | + | − | 0.38 ± 0.01 | 0.49 ± 0.18 | 311.36 |
| DHA55 | Rod | + | + | + | + | + | − | 0.40 ± 0.01 | 0.54 ± 0.20 | 393.14 |
| Genes | Size (bp) | Best Matches in GenBank | Organism/Isolate for Best Matches | BlastN e Value | Nucleotide Identity (%) |
|---|---|---|---|---|---|
| Iturin C | 450 | ALA39967.1 | B. amyloliquefaciens | 0.0 | 98.60 |
| Iturin B | 473 | MBM7358087.1 | B. velezensis | 0.0 | 98.67 |
| Iturin D | 493 | QBY06353.1 | B. amyloliquefaciens | 0.0 | 95.81 |
| Fengycin E | 704 | ACX55806.1 | B. amyloliquefaciens | 0.0 | 97.31 |
| Fengycin D | 167 | AGU42446.1 | B. amyloliquefaciens | 8 × 10−79 | 100 |
| Surfactin | 202 | QPC9684.1 | B. velezensis | 3 × 10−89 | 92.31 |
| C14:0 iso | C15:0 iso | C15:0 anteiso | C16:0 iso | C16:0 | C17:0 iso | C17:0 anteiso |
|---|---|---|---|---|---|---|
| 1.65 | 15.20 | 32.76 | 15.20 | 13.27 | 5.93 | 6.79 |
Disclaimer/Publisher’s Note: The statements, opinions and data contained in all publications are solely those of the individual author(s) and contributor(s) and not of MDPI and/or the editor(s). MDPI and/or the editor(s) disclaim responsibility for any injury to people or property resulting from any ideas, methods, instructions or products referred to in the content. |
© 2023 by the authors. Licensee MDPI, Basel, Switzerland. This article is an open access article distributed under the terms and conditions of the Creative Commons Attribution (CC BY) license (https://creativecommons.org/licenses/by/4.0/).
Share and Cite
Al-Mutar, D.M.K.; Alzawar, N.S.A.; Noman, M.; Azizullah; Li, D.; Song, F. Suppression of Fusarium Wilt in Watermelon by Bacillus amyloliquefaciens DHA55 through Extracellular Production of Antifungal Lipopeptides. J. Fungi 2023, 9, 336. https://doi.org/10.3390/jof9030336
Al-Mutar DMK, Alzawar NSA, Noman M, Azizullah, Li D, Song F. Suppression of Fusarium Wilt in Watermelon by Bacillus amyloliquefaciens DHA55 through Extracellular Production of Antifungal Lipopeptides. Journal of Fungi. 2023; 9(3):336. https://doi.org/10.3390/jof9030336
Chicago/Turabian StyleAl-Mutar, Dhabyan Mutar Kareem, Noor Salih Abduljaleel Alzawar, Muhammad Noman, Azizullah, Dayong Li, and Fengming Song. 2023. "Suppression of Fusarium Wilt in Watermelon by Bacillus amyloliquefaciens DHA55 through Extracellular Production of Antifungal Lipopeptides" Journal of Fungi 9, no. 3: 336. https://doi.org/10.3390/jof9030336
APA StyleAl-Mutar, D. M. K., Alzawar, N. S. A., Noman, M., Azizullah, Li, D., & Song, F. (2023). Suppression of Fusarium Wilt in Watermelon by Bacillus amyloliquefaciens DHA55 through Extracellular Production of Antifungal Lipopeptides. Journal of Fungi, 9(3), 336. https://doi.org/10.3390/jof9030336

